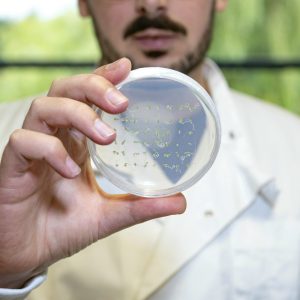

An exciting new landscape of protein-related discovery unfolds
An investigation into cellular components in bacteria has unexpectedly uncovered a feature with relevance across many life forms, paving the way for diverse research, biotechnical and medical applications
Read the story